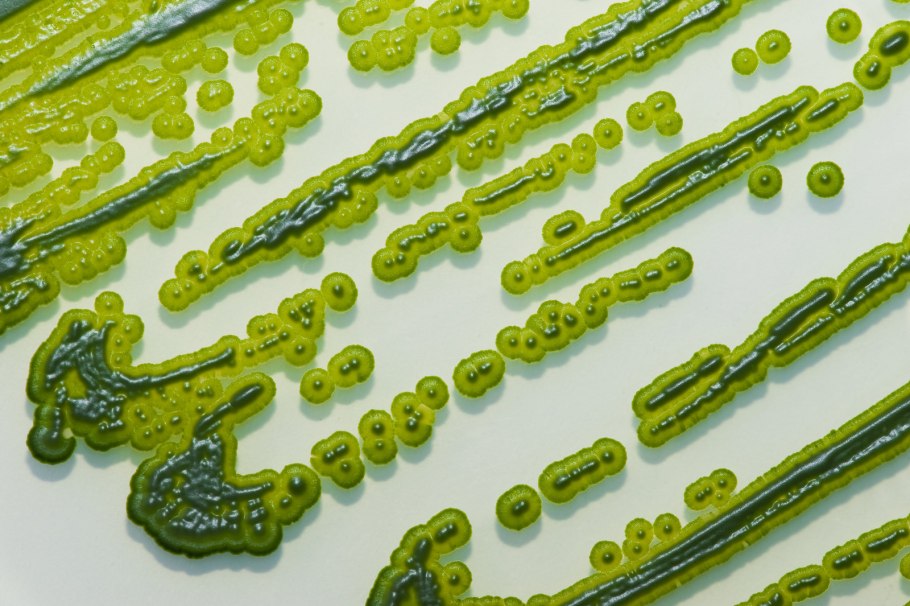

Водоросли цианобактерии

Синезеленые цианобактерии

Диатомовые синезеленые водоросли

Фотосинтезирующие цианобактерии

Сине-зеленые водоросли цианобактерии

Фотосинтезирующие цианобактерии

Синезелёные водоросли цианобактерии

Синезеленые цианобактерии

Цианеи сине зеленые водоросли

Цианобактерии или сине-зеленые водоросли

Зеленые водоросли фитопланктон

Носток цианобактерия

Одноклеточные колониальные и многоклеточные водоросли

Фотосинтезирующие бактерии цианобактерии

Цветение воды цианобактерии

Спирулина цианобактерия

Синезеленые цианобактерии

Синезеленые цианобактерии

Синезелёные водоросли цианобактерии

Цветение воды цианобактерии

Синезеленые цианобактерии

Сине-зеленые водоросли цианобактерии
Синезеленые цианобактерии

Сине-зеленые водоросли цианобактерии

Цианобактерии водоросли

Сине-зеленые водоросли цианобактерии

Прокариоты цианобактерии

Фотосинтезирующие бактерии цианобактерии

Цианобактерии осциллятория

Синезелёные водоросли цианобактерии

Цианобактерии Анабена

Синезеленые водоросли строение

Носток цианобактерия

Цианобактерия Oscillatoria

Сине-зеленые водоросли цианобактерии

Хлорелла цианобактерии

Цианобактерии носток Анабена

Сине-зеленые водоросли цианобактерии

Нитчатые цианобактерии

Nostoc цианобактерия

Цианобактерии спирулина

Цианобактерии в водоеме

Цианобактерии в воде

Синезеленые цианобактерии

Фотосинтезирующие цианобактерии

Цианобактерии хлоропласты

Ционю бактерии сине-зеленые водоросли

Хлорелла цианобактерии

Цветение воды цианобактерии

Цианобактерии микроцистис

Синезелёные водоросли цианобактерии вредные

Нитчатые цианобактерии

Бактерии и цианобактерии

Цветение воды цианобактерии

Сине-зеленые водоросли цианобактерии

Токсичные водоросли

Эвтрофикация воды черного моря

Цветение воды водоросли цианобактерии

Строение клетки цианобактерий

Синезеленые цианобактерии

Синезелёные водоросли цианобактерии

Цианобактерия Anabaena

Цианобактерии царство

Цианеи водоросли

Строение клетки цианобактерий

Синезелёные водоросли цианобактерии

Blue Green algae

Гиелла это цианобактерия

Одноклеточная водоросль хлорелла

Древние цианобактерии

Anabaena водоросль

Формидиум водоросль

Цианобактерия анабена

Микроводоросли chlorella vulgaris

Цианобактерии в микроскопе
Поделиться фото в социальных сетях:
Комментариев (0)
Похожие фото:











